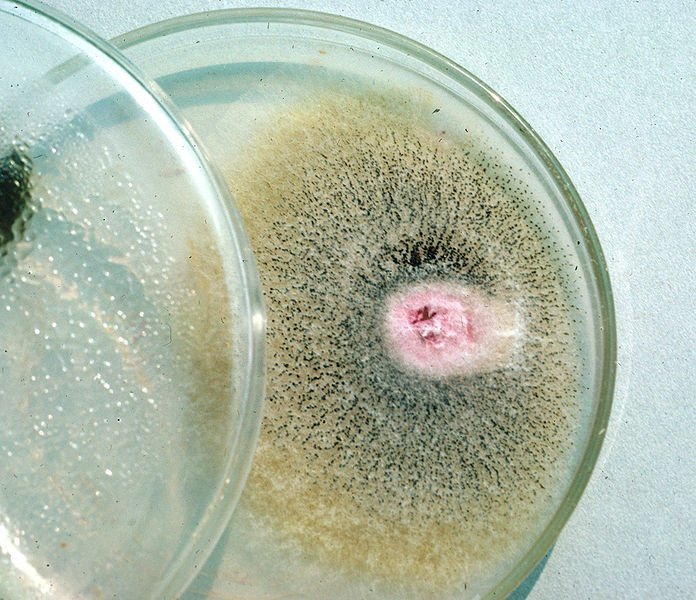
HomeTestingPros's tweet image. Cheap or Inexpensive Testing is NOT safe

To save heartache, hire experienced Mold Testing professionals. Don't hire anyone you find on Google  with a lack of expertise will miss the cause of your health problems!!! Don’t waste time and money! hometestingpros.com/request-for-te…

You might like
An updated and reorganized Paradigm Change website page, listing media stories on toxic mold illness #moldillness #mold #toxicmold paradigmchange.me/media-articles/
#WIN: one of four, €50 One4All vouchers Our new #AsthmaFreindlyHomes leaflet details the most common indoor asthma triggers and how to combat them. For your chance to win the first voucher, simply download the leaflet and retweet this tweet. Download now: bit.ly/2DcGSeq

Cheap or Inexpensive Testing is NOT safe To save heartache, hire experienced Mold Testing professionals. Don't hire anyone you find on Google with a lack of expertise will miss the cause of your health problems!!! Don’t waste time and money! hometestingpros.com/request-for-te…
What are some of the PROS and CONS of Tape lift, bulk and Swab mold sampling? hometestingpros.com/pros-and-cons-…

Could something in your home be making you sick? Get your home tested today and protect your health and your investment: HomeTestingPros.com #toxicmold #moldtesting #CIRS #environmentalillness #moldillness #mold

Chemical sources of exposure and health issues continue to be strongly in the air (pun intended!). Here's a specific one.
We are proud to help support an amazing #documentary about one of the biggest #environmental scandals of our time. Watch it to today on iTunes, Amazon, or Google Play - THE DEVIL WE KNOW (@DevilWeKnowFilm) #TossTheTeflon
Could something in your home be making you sick? #MoldIllness #ToxicMold #MoldTesting #VOC #DustMites @Chemicals HomeTestingPros.com @HomeTestingPros

United States Trends
- 1. Kawhi N/A
- 2. Wemby N/A
- 3. #NBAAllStar2026 N/A
- 4. #Daytona500 N/A
- 5. Jaylen Brown N/A
- 6. Anthony Edwards N/A
- 7. Jokic N/A
- 8. Tyler Reddick N/A
- 9. Team World N/A
- 10. #RHOP N/A
- 11. LeBron N/A
- 12. Michael Jordan N/A
- 13. NASCAR N/A
- 14. Team Stripes N/A
- 15. Brandy N/A
- 16. Jamal Murray N/A
- 17. Kevin Durant N/A
- 18. East vs West N/A
- 19. The Klaw N/A
- 20. Herbst N/A
You might like
Something went wrong.
Something went wrong.









































































